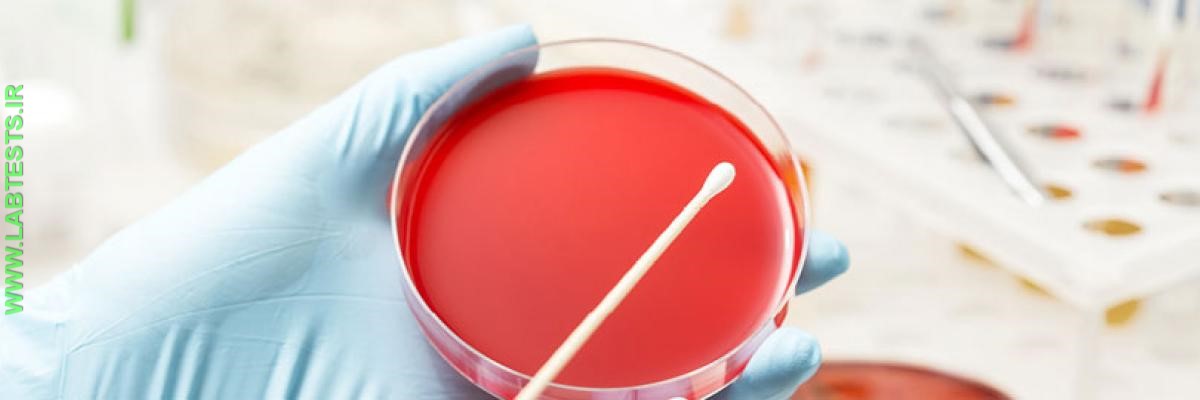
Throat culture

This article was
last reviewed
on
This article waslast modified
on April 2, 2018.
Your healthcare practitioner takes a swab of your throat to test for an infection. Ever wonder what happens to your sample once it's been collected? It's sent "to the lab" for culturing, but what does that entail? This article will take you on a tour as a throat culture is processed.
In the laboratory, trained laboratorians use various methods to analyze your sample as determined by what types of tests you need performed. The Who's Who in the Lab article introduces you to these lab personnel.
For every test, there is an appropriate sample that provides the best information for that test. To learn about other types of body samples besides blood and throat swabs that can be collected for analysis, see the article Collecting Samples for Testing.
-
Collecting the culture sample

A culture is a test that is often used to detect infections. It involves collecting a sample from the site of infection and inoculating the sample into solid or liquid nutrient media (e.g., agar, gelatin) in order to grow any microorganisms like bacteria or fungi that may be present.
Cultures can be performed on a variety of body samples, including blood, urine, stool, sputum, and pus from a wound. Collection methods therefore depend on where the suspected infection is located and the type of sample being taken. The example pictured here is a throat culture where a swab is rubbed over the back of the throat to collect a sample for culture.
-
Labeling the culture sample

After the throat sample has been collected, the swab is put into a transport tube to prevent it from getting contaminated or drying out, and the transport tube is labeled. In many places, the label may be pre-printed with the patient's name and unique patient identification number or barcoded with that information.
-

After the sample has been labeled, it is transported to the lab where it will be logged in to the laboratory information system. Once it arrives in the lab, however near or far away, the sample will be recorded in the laboratory's tracking system. The label contains all the information necessary to ensure that the results of the test on the sample are matched to the correct person. Usually, a written or electronic requisition form listing the health practitioner's name and address (in addition to the patient's information) is sent with the sample so the results can be sent back to the appropriate person.
-

Once in the lab, a laboratorian will transfer the throat sample that is on the swab to nutrient media, such as a blood agar plate, that will allow the growth of bacteria. In the photo above, the swab is being gently rubbed over the surface of the agar.
-

The labeled agar plate is placed in an incubator, which is a chamber that maintains a constant temperature similar to your body temperature and a specific percentage of carbon dioxide that is optimal for the growth of the bacteria. The culture of the throat sample usually remains in the incubator for 18 to 24 hours to allow sufficient time for any bacteria that may be present to grow.
-

After incubation, a laboratory professional will visually examine the culture. Some bacteria have a characteristic appearance that enables the laboratory professional to presumptively identify the specific bacteria, but additional biochemical or serological tests are usually needed to make the identification. The laboratory professional must distinguish potential pathogenic bacteria from normal throat flora that are not harmful and don't require treatment.
-

The most common bacterial cause of a sore throat is an infection with group A streptococcus. If these harmful bacteria have been identified in the throat culture, then the affected person will be treated with antibiotics. Because the appropriate antibiotic therapy is predictable for group A streptococcal infection, no further testing is usually necessary.
However, other types of cultures that are positive for pathogenic bacteria may require an antibiotic susceptibility test, which grows the bacteria in the presence of a panel of antibiotics to see which antibiotics may be effective for treating the infection. For one example of a susceptibility method, the bacteria are swabbed onto an agar plate and antibiotics that are impregnated into filter paper disks are placed on the plate. Following an overnight incubation step, the absence of bacterial growth around the disk indicates the ability of that antibiotic to inhibit the bacteria. The results of this test inform the health practitioner which antibiotic to prescribe to cure the infection.
-

The culture results will be recorded in the laboratory information system. The results may be sent to the health practitioner electronically, via fax, written copy, or by telephone.